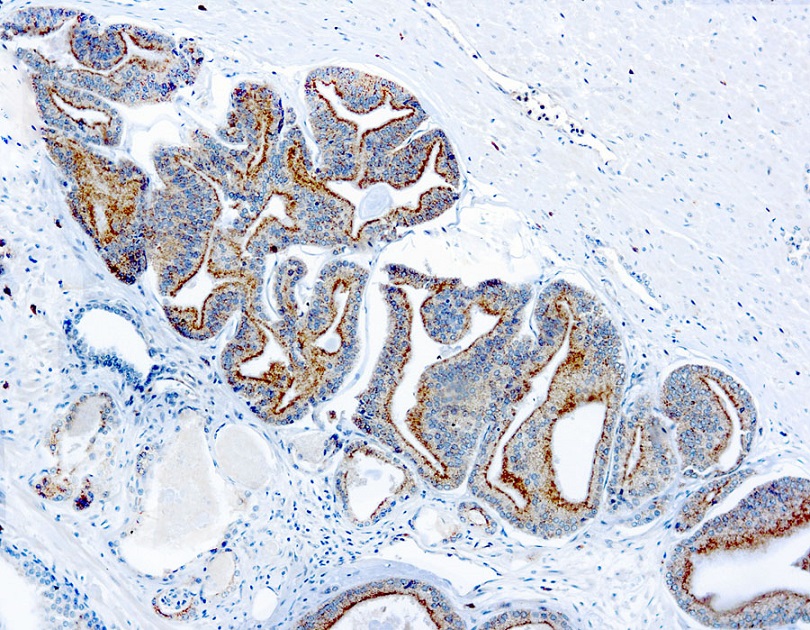

p504S/Alpha-Methylacyl-CoA Racemase (AMACR) (13H4)
P504S has been recently described as a prostate cancer-specific gene that encodes a protein involved in the ?-oxidation of branched chain fatty acids. Expression of p504S protein is found in prostatic adenocarcinoma but not in benign prostatic tissue. It stains premalignant lesions of prostate: high-grade prostatic intraepithelial neoplasia (PIN) and atypical adenomatous hyperplasia. P504S can be used as a positive marker for PIN.
0,5 ml
| Clone | 13H4 |
| Isotype | IgG1 |
| Application | IHC |
| Host | Rabbit |
La documentación estará disponible en breve, mientras tanto, puede contactarnos por correo electrónico a specialist@histoline.com